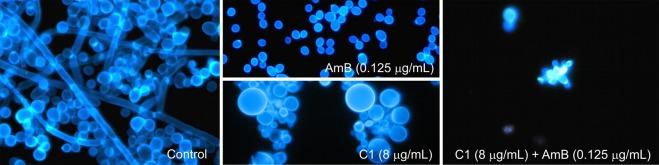
https://cdn.ncbi.nlm.nih.gov/pmc/blobs/8dfe/6737028/609462792afd/41598_2019_49425_Fig3_HTML.jpg

两性霉素 B 与 4-(5-甲基-1,3,4-噻二唑-2-基)苯-1,3-二醇的协同抗真菌相互作用。
Synergistic antifungal interactions of amphotericin B with 4-(5-methyl-1,3,4-thiadiazole-2-yl) benzene-1,3-diol.
机构信息
Department of Cell Biology, Institute of Biology and Biochemistry, Maria Curie-Skłodowska University, Akademicka 19, 20-033, Lublin, Poland.
Department of Anaesthesiology and Intensive Therapy Medical University of Lublin, Jaczewskiego 8, 20-954, Lublin, Poland.
出版信息
Sci Rep. 2019 Sep 10;9(1):12945. doi: 10.1038/s41598-019-49425-1.
Amphotericin B (AmB) is a very potent antifungal drug with very rare resistance among clinical isolates. Treatment with the AmB formulations available currently is associated with severe side effects. A promising strategy to minimize the toxicity of AmB is reducing its dose by combination therapy with other antifungals, showing synergistic interactions. Therefore, substances that display synergistic interactions with AmB are still being searched for. Screening tests carried out on several dozen of synthetic 1,3,4-thiadiazole derivatives allowed selection of a compound called 4-(5-methyl-1,3,4-thiadiazole-2-yl) benzene-1,3-diol (abbreviated as C1), which shows strong synergistic interaction with AmB and low toxicity towards human cells. The aim of the present study was to investigate the type of in vitro antifungal interactions of the C1 compound with AmB against fungal clinical isolates differing in susceptibility. The results presented in the present paper indicate that the C1 derivative shows strong synergistic interaction with AmB, which allows the use of a dozen to several dozen times lower AmB concentration necessary for 100% inhibition of the growth of pathogenic fungi in vitro. Synergistic interactions were noted for all tested strains, including strains with reduced sensitivity to AmB and azole-resistant isolates. These observations give hope for the possibility of application of the AmB - C1 combinatory therapy in the treatment of fungal infections.
两性霉素 B(AmB)是一种非常有效的抗真菌药物,在临床分离株中非常罕见有耐药性。目前使用的 AmB 制剂治疗与严重的副作用有关。通过与其他抗真菌药物联合治疗来减少 AmB 的剂量是一种很有前途的策略,可以减少其毒性,显示出协同作用。因此,仍然在寻找与 AmB 显示协同作用的物质。对几十种合成 1,3,4-噻二唑衍生物进行的筛选试验,选择了一种名为 4-(5-甲基-1,3,4-噻二唑-2-基)-苯-1,3-二醇(简称 C1)的化合物,该化合物与 AmB 显示出强烈的协同作用,对人细胞的毒性较低。本研究的目的是研究 C1 化合物与 AmB 对不同敏感性的临床真菌分离株的体外抗真菌相互作用的类型。本文介绍的结果表明,C1 衍生物与 AmB 具有强烈的协同作用,这使得可以使用低至 100%抑制体外致病性真菌生长所需的 AmB 浓度的十几倍至几十倍。所有测试的菌株都显示出协同作用,包括对 AmB 敏感性降低的菌株和唑类耐药分离株。这些观察结果为 AmB-C1 联合治疗在治疗真菌感染中的应用提供了希望。